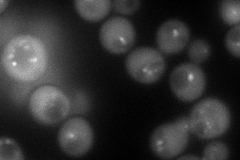
YKR035W-A
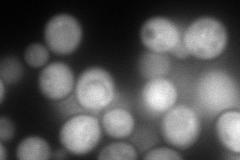
YKR035W-A
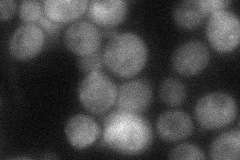
YKR035W-A
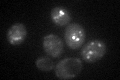
YKR035W-A

View description
Class E protein of the vacuolar protein-sorting (Vps) pathway; binds Vps4p and directs it to dissociate ESCRT-III complexes; forms a functional and physical complex with Ist1p; human ortholog may be altered in breast tumors
Localization:
Intensity:
Fold change:
Significance:
-
C’ GFP library in SD

punctate63.37 -
N' NOP1pr-GFP in SD
cytosol,punctate128.961 -
N' TEF2pr-mCherry in SD
cytosol209.485 -
N' NATIVEpr-GFP in SD
cytosol44.3004 -
N' TEF2pr-VC and Cyto-VN in SD

cytosol58.1606 -
C’ GFP library in SD+DTT

punctate70.21.1No -
C’ GFP library in SD+H2O2
punctate37.410.59Yes -
C’ GFP library in Starvation Media

punctateN/AN/AYes -
C’ GFP library on the background of Pup2-DaMP

punctate -
C’ GFP library on the background of CCT mutant

punctate64.52911.01809No
